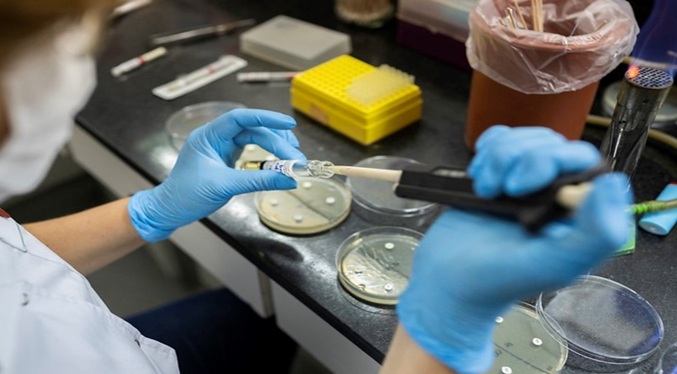
Los casos de la variante K de la influenza A H3N2 ascienden a 28 en Argentina

Argentina expulsa a venezolano acusado de tener vínculos con el Tren de Aragua
Un ciudadano venezolano acusado de vínculos con la organización criminal transnacional Tren de Aragua, detenido en diciembre por las fuerzas de seguridad de Argentina, fue expulsado a su país de origen, según informó este viernes el Ministerio de Seguridad Nacional argentino.
“Bajo lineamientos del Ministerio de Seguridad Nacional, el Departamento Federal de Investigaciones (DFI) de la Policía Federal Argentina concretó la expulsión del país de un ciudadano venezolano imputado por el delito de asociación ilícita, en el marco de una causa judicial vinculada a la organización criminal internacional conocida como Tren de Aragua”, anunció el Ministerio en un comunicado.
Tras su detención el 20 de diciembre pasado en una localidad de la provincia de Corrientes (norte), que limita con Pa...